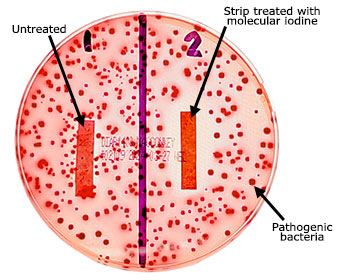

Healthcare: A departure from surface-level only disinfection for the skin and medical devices
With the formulation of Lugol’s Solution in 1829, iodine has been a key component of global healthcare for hundreds of years. Lugol’s Solution itself remains on the list of the World Health Organization’s list of essential medicines.
A natural element with inherent biocidal capabilities, iodine interacts with pathogens at a cellular level, destroying their proteins and killing them. At the same time, this incredible element is remarkably biocompatible in humans and animals. Every vertebrate on planet Earth creates molecular iodine as a part of its immune system. In humans, this is done within the follicular lumen and is critical to the formation of thyroid hormones. In fact, a lack of iodine ingestion is a well-known contributor to severe human health adversities.
On the foundation of hundreds of years of use in global healthcare, the healthcare industry is a natural point of emphasis for I2Pure. With a near-term emphasis on skin and wound applications, I2Pure is acutely focused on the development of products serving global healthcare needs.
We are currently in final development of products for skin antisepsis, wound irrigation, wound treatment and healing, dermal scaffolding, and bandage coatings, among others.
The image illustrates I
2 at work.
Consumer Products: We are focused on helping you have healthy skin.

I2Pure is committed to bringing the power of molecular iodine to play wherever it can help people. With inherent anti-inflammatory properties, molecular iodine is a perfect ingredient for products intended to make skin feel and look better. Whether reducing blemishes or improving skin aesthetics, I2Pure cosmetic and over-the-counter consumer products are a perfect addition to daily skin care regimens.
I2Pure has developed several lotions designed to partition molecular iodine deep into the skin. These lotions moisturize the skin and are composed of 100% natural ingredients. The molecular iodine provides an added antiseptic property.
The first of these to go to market in the United States is "i2•Results", a serum to use on clean skin twice per day to treat blemishes, smooth the skin and reduce redness.